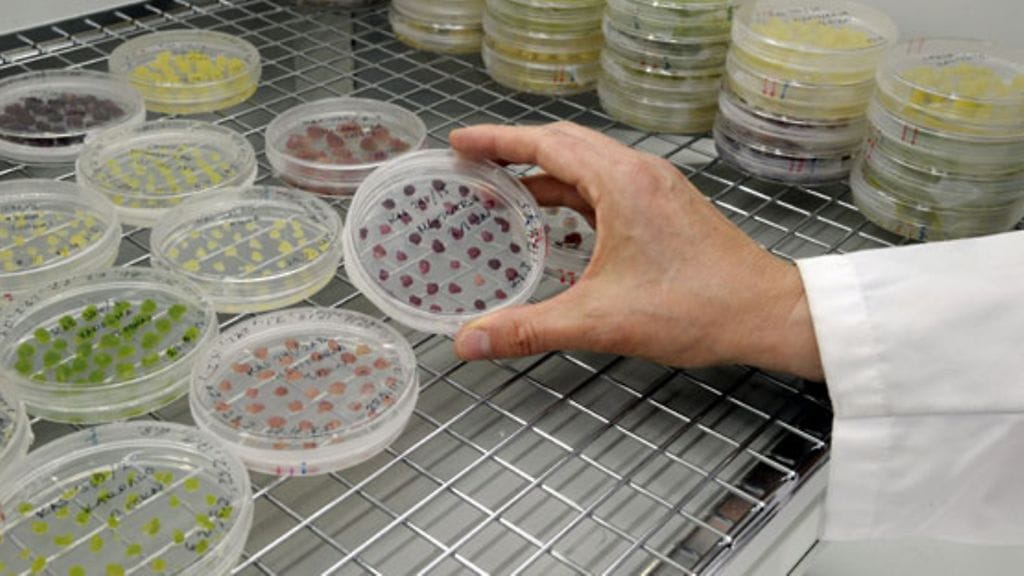
Kuvassa suomalaisista marjoista tuotettuja kantasoluviljelmiä, joita kosmetiikkateollisuuskin voi hyödyntää.

Lumenen tuotekehityksestä vastaava johtaja Tiina Isohanni kertoo, mihin aineisiin anti age-tuotteiden vaikutus perustuu.
Anti age-tuotteissa voidaan käyttää monia erilaisia raaka-aineita. Sisällöt vaihtelevat yrityksestä riippuen.
– Aurinkosuoja-aineet ovat erittäin tärkeitä vanhenemisen merkkien ennaltaehkäisyyn. Hyviä tutkimustuloksia on saatu myös retinoleista eli a-vitamiinihapoista. Viime aikoina myös peptidit eli aminohapot ovat tulleet suositummiksi. Niitä valmistetaan bioteknologian avulla, Tiina Isohanni kertoo.
Bioteknologiaa käytetään kosmetiikkateollisuudessa hyvin yleisesti.
– Se on luonnollista teknologiaa, mutta ei kuitenkaan suoraan luonnosta. Sen sijaan eri tyyppisten kasvien kantasoluissa, joita anti age-tuotteissa myös käytetään, lähtökohtana ovat nimenomaan kasvin aivan omat solut. Niistä vain kasvatetaan laboratoriossa edelleen kantasoluja, Isohanni selittää.
– Toki kosmetiikassa hyödynnetään myös erilaisia kasviuutteita. Lumenella käytämme esimerkiksi marjojen siemenöljyjä, jotka ovat selkeästi luonnon raaka-aineita.
Studio55.fi/Piia Simola
Näin anti age -voiteiden tehokkuutta tutkitaan
Täältä saadaan ihovoiteiden koetestaajat
"Kiinteyttävä" ja "heleyttävä"? Näin ihovoiteiden vaikutuksia mitataan